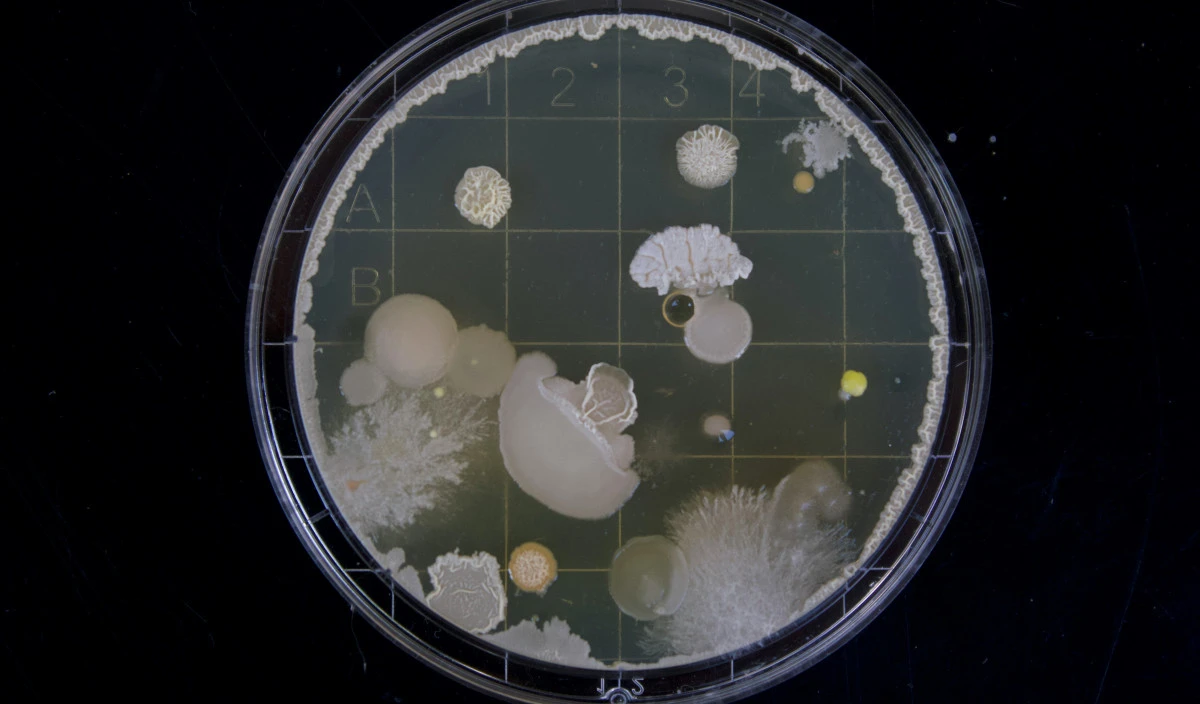

Solve problems in and around your home.
Start Problem Solver
Bacteria are microscopic single celled organisms. Some can cause disease but most are beneficial or harmless.
Bacteria are not visible to the naked eye individually but can be seen when in very large numbers. There effects can be seen as they form part of the ecosystem that breaks down (rots) organic material such as food waste, compost, dead animals etc. They can also mark surfaces along with algae and moulds.
On surfaces where bacteria can grow they should be cleaned off and the surface sanitised to kill remaining bacteria.
On hands and contaminated skin bacteria can be washed off and skin sanitised.
A powerful anti-bacterial liquid spray that removes mould & soap scum from hard surfaces.
NO Germs Hand Sanitiser leaves hands clean, smooth and free of germs. Ideal for use around the home, workplace a…
For protection against germs and bacteria ensure regular hand washing with SORTED Anti-Bacterial Hand Wash. Reme…